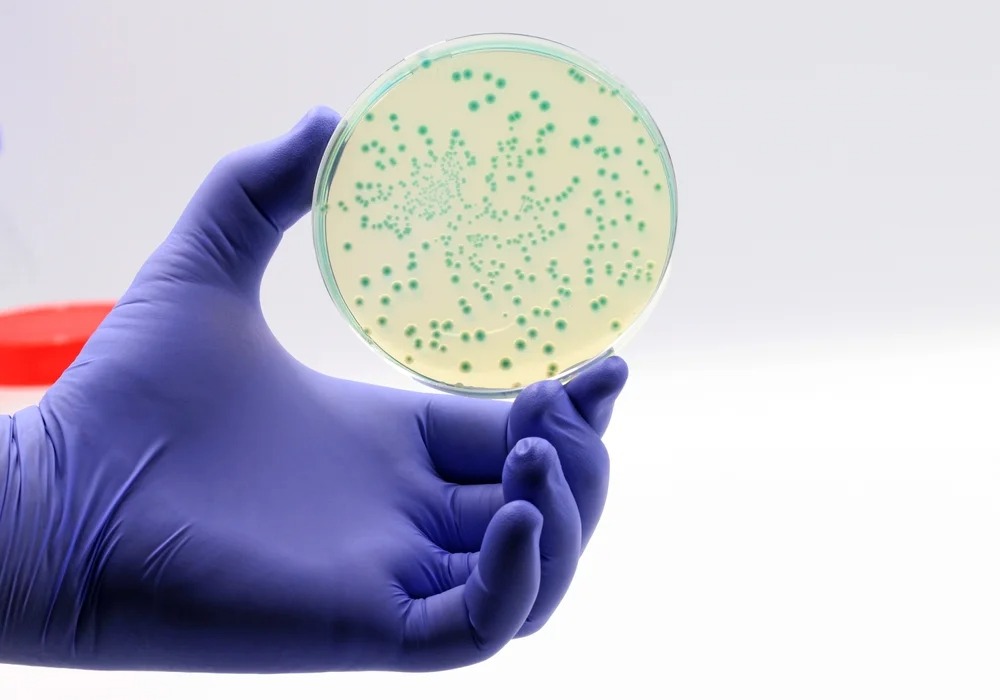

Hội chứng ruột kích thích (IBS) – Nguyên nhân và cách điều trị
Mục lục
- Hội chứng ruột kích thích (IBS) là gì?
- Nguyên nhân gây hội chứng ruột kích thích
- Dấu hiệu của hội chứng ruột kích thích
- Những đối tượng có nguy cơ mắc hội chứng ruột kích thích
- Phương pháp chẩn đoán hội chứng ruột kích thích
- Hội chứng ruột kích thích có nguy hiểm không?
- Cách điều trị hội chứng ruột kích thích
- Phòng ngừa hội chứng ruột kích thích hiệu quả
Hội chứng ruột kích thích là tình trạng rối loạn tiêu hóa khá phổ biến. Tuy nhiên, mọi người vẫn thường nhầm lẫn tình trạng này với các bệnh lý về đường tiêu hóa khác dẫn tới có phương pháp điều trị không phù hợp. Bài viết dưới đây a:care Việt Nam sẽ cung cấp cho bạn đọc các thông tin cần thiết về hội chứng ruột kích thích.
Hội chứng ruột kích thích (IBS) là gì?
Hội chứng ruột kích thích (IBS) là một rối loạn tiêu hóa phổ biến. Các triệu chứng thường gặp bao gồm đau hoặc đau quặn bụng, đầy hơi, tiêu chảy, táo bón hoặc cả hai. IBS là một tình trạng mạn tính, cần kiểm soát lâu dài thông qua quản lý chế độ ăn uống, lối sống và kiểm soát căng thẳng.

Nguyên nhân gây hội chứng ruột kích thích
Hiện nay nguyên nhân chính xác gây hội chứng ruột kích thích vẫn chưa được xác định. Tuy nhiên, một vài yếu tố có thể gây ra hoặc làm trầm trọng triệu chứng ruột kích thích như:
- Căng thẳng
Khi bạn căng thẳng hoặc lo lắng có thể làm kích hoạt và trầm trọng thêm triệu chứng hội chứng ruột kích thích. IBS có thể liên quan tới sức khỏe tinh thần. Điển hình như những người mắc chứng rối loạn căng thẳng sau chấn thương có nguy cơ mắc IBS cao hơn người bình thường.
- Sự co thắt cơ trong ruột
Thành ruột được lót bằng các lớp cơ. Lớp này sẽ co bóp nhịp nhàng trong quá trình vận chuyển thức ăn qua đường tiêu hóa. Khi các cơn co thắt mạnh hơn và kéo dài hơn bình thường dẫn đến đầy hơi, chướng bụng và tiêu chảy. Ngược lại, khi ruột co thắt yếu, quá trình vận chuyển thức ăn sẽ diễn ra chậm làm cho phân trở nên cứng và khô.
- Mất cân bằng hệ vi sinh vật
Yếu tố vi sinh vật có thể đóng một vai trò quan trọng đối với hội chứng ruột kích thích. Đôi khi sự phát triển quá mức của các vi khuẩn có trong đường ruột (loạn khuẩn) có thể gây kích thích đường ruột. Phương pháp điều trị giúp cân bằng hệ vi sinh vật có thể giúp giảm bớt các triệu chứng.
- Chế độ ăn
Chế độ ăn uống đóng một vai trò quan trọng trong việc kích hoạt các triệu chứng của IBS. Một số người khi tiêu thụ các thực phẩm như socola, sữa, rượu,… sẽ khiến triệu chứng trở nên trầm trọng hơn. Một số loại trái cây, rau và nước ngọt cũng có thể gây ra đầy hơi và khó chịu cho người bị IBS.
Một vài yếu tố khác như: Sự thay đổi hormone, yếu tố di truyền, phản ứng với thuốc,… cũng có thể là nguyên nhân gây ra triệu chứng IBS.
Dấu hiệu của hội chứng ruột kích thích
Các dấu hiệu của hội chứng ruột kích thích xuất hiện và biến mất không theo bất kỳ chu kỳ nào. Một số hoặc tất cả các triệu chứng IBS có thể xảy ra cùng một lúc. Các triệu chứng có thể khác nhau, đôi khi tiêu chảy có thể xen kẽ với táo bón.
- Đau bụng: Đau bụng là triệu chứng chính của IBS và thường thuyên giảm sau khi đi tiêu. Các cơn đau bụng thường xảy ra ở vùng bụng dưới hoặc toàn bộ vùng bụng. Cơn đau có thể bắt đầu khi tần suất đi tiêu nhiều hơn hoặc ít hơn. Các cơn đau bụng cũng có thể bắt đầu khi phân thay đổi, trở nên cứng hơn hoặc mềm hơn.

- Đầy hơi: Quá trình tiêu hóa bị thay đổi dẫn đến sản xuất nhiều khí hơn trong ruột gây đầy hơi, khó chịu. Nhiều người mắc IBS cho biết đầy hơi là một trong những triệu chứng dai dẳng nhất của hội chứng này.
- Tiêu chảy: Khi mắc IBS, bạn có thể xuất hiện tình trạng đi tiêu phân lỏng, đôi khi cần đi tiêu đột ngột.
- Táo bón: IBS thể táo bón ước tính ảnh hưởng tới khoảng 35% số người mắc IBS, người bệnh phải rặn nhiều khi đi đại tiện và cảm thấy như đi ngoài không hết phân.
Một số dấu hiệu khác của IBS: mệt mỏi và thiếu năng lượng, buồn nôn, đau lưng, đi tiểu thường xuyên, đi tiêu không tự chủ,…
Những đối tượng có nguy cơ mắc hội chứng ruột kích thích
Hội chứng ruột kích thích có thể gặp ở bất kỳ đối tượng nào. Tuy nhiên, thường xảy ra hơn ở những người dưới 50 tuổi. Hoặc, bạn có nhiều nguy cơ mắc ruột kích thích hơn nếu:
- Có tiền sử gia đình bị IBS: Gen và các yếu tố sinh hoạt chung trong môi trường gia đình có thể làm gia tăng nguy cơ bị hội chứng ruột kích thích.
- Gặp các vấn đề về sức khỏe tâm thần, bị lo lắng hoặc trầm cảm
- Thường gặp ở phụ nữ: IBS được đánh giá là phổ biến ở nữ giới hơn là nam giới.
Phương pháp chẩn đoán hội chứng ruột kích thích
Hiện nay chưa có hình ảnh hay xét nghiệm nào giúp chẩn đoán chính xác hội chứng ruột kích thích. Các bác sĩ sẽ chẩn đoán dựa trên các triệu chứng lâm sàng, tình trạng sức khỏe của người bệnh và loại trừ các bệnh lý đường tiêu hóa khác như bệnh celiac và bệnh viêm ruột (IBD).
– Sau khi các bệnh lý tiêu hóa khác được loại trừ, bác sĩ sẽ chẩn đoán IBS dựa trên các bộ tiêu chí dưới đây:
- Tiêu chí Rome: Các tiêu chí này bao gồm bệnh nhân cảm thấy đau bụng hoặc khó chịu ít nhất 1 ngày/tuần trong vòng 3 tháng gần nhất và kết hợp với ít nhất 2 trong số các điều kiện sau: Đau hoặc khó chịu có liên quan đến đại tiện và tần suất đại tiện hoặc độ đặc của phân thay đổi.
- Loại IBS: Với mục đích điều trị, IBS có thể được chia thành bốn loại, dựa trên các triệu chứng của bạn: IBS thể táo bón, IBS thể tiêu chảy, IBS hỗn hợp hoặc không được phân loại.
– Hoặc bác sĩ có thể hỏi thêm về các triệu chứng như:
- Có thay đổi về thói quen đi đại tiện, ví dụ như tiêu chảy hay táo bón không?
- Có đau hay khó chịu ở bụng không?
- Thường có cảm giác đầy hơi trong bao lâu?
– Xét nghiệm máu: Xét nghiệm máu là phương pháp chẩn đoán cận lâm sàng giúp loại trừ các tình trạng khác hội chứng ruột kích thích như: bất dung nạp lactose, bệnh celiac, sự phát triển quá mức của vi khuẩn trong đường ruột,…
Hội chứng ruột kích thích có nguy hiểm không?
Các triệu chứng của hội chứng ruột kích thích (IBS) có thể gây rối loạn và làm giảm chất lượng cuộc sống của những người bị ảnh hưởng. Tuy nhiên, chúng không gây ra nguy cơ phát triển các bệnh nghiêm trọng.
Ngoài ra, IBS kéo dài có thể gây:
- Ảnh hưởng chất lượng cuộc sống: Nghiên cứu chỉ ra rằng những người mắc IBS phải nghỉ làm nhiều gấp ba lần so với những người không bị IBS.
- Rối loạn tâm trạng: Trải qua các triệu chứng của IBS có thể dẫn đến trầm cảm hoặc lo lắng. Mà trầm cảm và lo lắng lại làm cho IBS trở nên tồi tệ hơn.
Cách điều trị hội chứng ruột kích thích
Theo hướng dẫn điều trị hội chứng ruột kích thích của Tổ chức tiêu hóa Thế Giới (WGO), các phương pháp điều trị được khuyên dùng dựa theo triệu chứng như:
Điều trị triệu chứng đau bụng, đầy hơi:
- Thuốc chống co thắt: Giúp làm thư giãn cơ trơn ruột do đó làm giảm nhu động ruột, cải thiện triệu chứng đau bụng. Các loại thuốc này cần được sử dụng theo hướng dẫn của bác sĩ, dược sĩ.
- Tinh dầu bạc hà: Tinh dầu bạc hà giúp làm giãn cơ trơn từ đó giúp giảm đau bụng, ngoài ra chúng còn có tác dụng kháng khuẩn và chống viêm trực tiếp và giảm stress.
- Chống trầm cảm ba vòng: Có thể giúp giảm trầm cảm và cũng có tác dụng giảm đau trong hội chứng ruột kích thích. Thuốc chống trầm cảm 3 vòng cần được kê toa và theo dõi chặt chẽ bởi bác sĩ điều trị.
Điều trị triệu chứng táo bón:
- Thuốc nhuận tràng: Nếu việc bổ sung chất xơ không giúp giảm tình trạng táo bón, bác sĩ có thể khuyên bạn dùng thuốc nhuận tràng.
- Bổ sung chất xơ: Chất xơ thường được khuyên dùng để cải thiện các triệu chứng táo bón ở người bệnh IBS. Bổ sung các chất xơ hòa tan có thể giúp cải thiện độ rắn của phân và tần suất đi tiêu.
Điều trị triệu chứng tiêu chảy:
- Thuốc cầm tiêu chảy: Các loại thuốc không kê đơn có thể giúp kiểm soát tiêu chảy. Bác sĩ cũng có thể chỉ định sử dụng chất liên kết với axit mật.

Ngoài ra, người mắc IBS được khuyến cáo nên sử dụng men vi sinh đối với bất kể loại IBS nào.
Phòng ngừa hội chứng ruột kích thích hiệu quả
Những thay đổi đơn giản trong chế độ ăn uống và lối sống sẽ giúp bạn phòng ngừa hội chứng ruột kích thích hiệu quả.
- Hạn chế sử dụng các thực phẩm, đồ uống làm trầm trọng thêm triệu chứng. Người bị IBS cũng nên hạn chế sử dụng các loại đồ uống có cồn, trà, đồ uống chứa caffein, đồ uống có ga,…
- Ăn vào giờ cố định: Hạn chế bỏ bữa và ăn vào một thời điểm cố định mỗi ngày sẽ giúp điều hòa chức năng ruột. Nếu bị tiêu chảy, ăn thành nhiều bữa có giúp cải thiện triệu chứng, nếu bị táo bón cần bổ sung đầy đủ chất xơ.
- Chất xơ giúp giảm táo bón nhưng cũng có thể làm nặng thêm tình trạng đầy hơi và đau quặn bụng. Hãy thử tăng từ từ lượng chất xơ trong chế độ ăn, trong khoảng vài tuần bằng các thực phẩm phù hợp.
- Luyện tập thể dục đều đặn: Tập thể dục giúp giảm trầm cảm và căng thẳng, giảm kích thích các cơn co thắt của ruột.
Bài viết trên a:care Việt Nam đã cung cấp nhiều thông tin bổ ích về hội chứng ruột kích thích. Hiểu rõ những thông tin bổ ích trên, hy vọng những người mắc hội chứng ruột kích thích đã có thêm cho mình kiến thức cũng như các phương pháp điều trị, cải thiện tình trạng này hiệu quả.
Xem thêm:
- Chung Sống Khỏe Mạnh Với Hội Chứng Ruột Kích Thích (IBS)
- Phương pháp kiểm soát hội chứng ruột kích thích hiệu quả
- Chuyện dạ dày – ruột: Giải pháp khắc phục khó tiêu và trào ngược dạ dày – thực quản